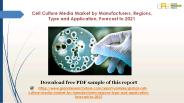
Cell Culture Media Market by Manufacturers, Regions, Type and Application, Forecast to 2021

File to download:
Title: Cell Culture Media Market by Manufacturers, Regions, Type and Application, Forecast to 2021 - PowerPoint PPT Presentation
Description: Cell Culture Media are used to provide nutrients for cell growth in research, diagnostic and manufacturing applications. Typical cell culture media contain a mixture of defined nutrients dissolved in a buffered physiological saline solution. – PowerPoint PPT presentation
Download instruction:
When the PPT version of this presentation was uploaded to PowerShow.com, it was checked for
viruses. That said, we cannot guarantee that the PPT file is safe for you to download. But if you
whish to download it, just check that you are not a robot and then click the download button.